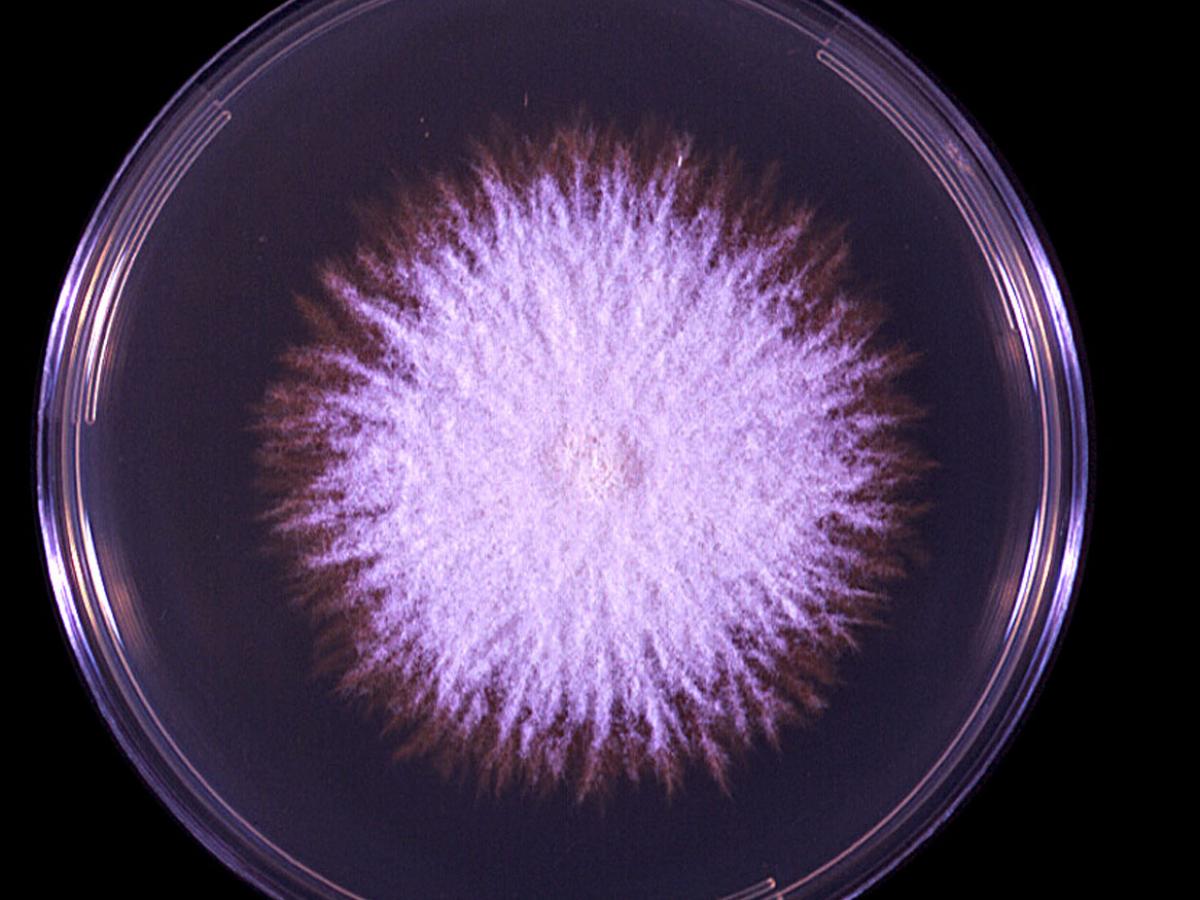
Culture
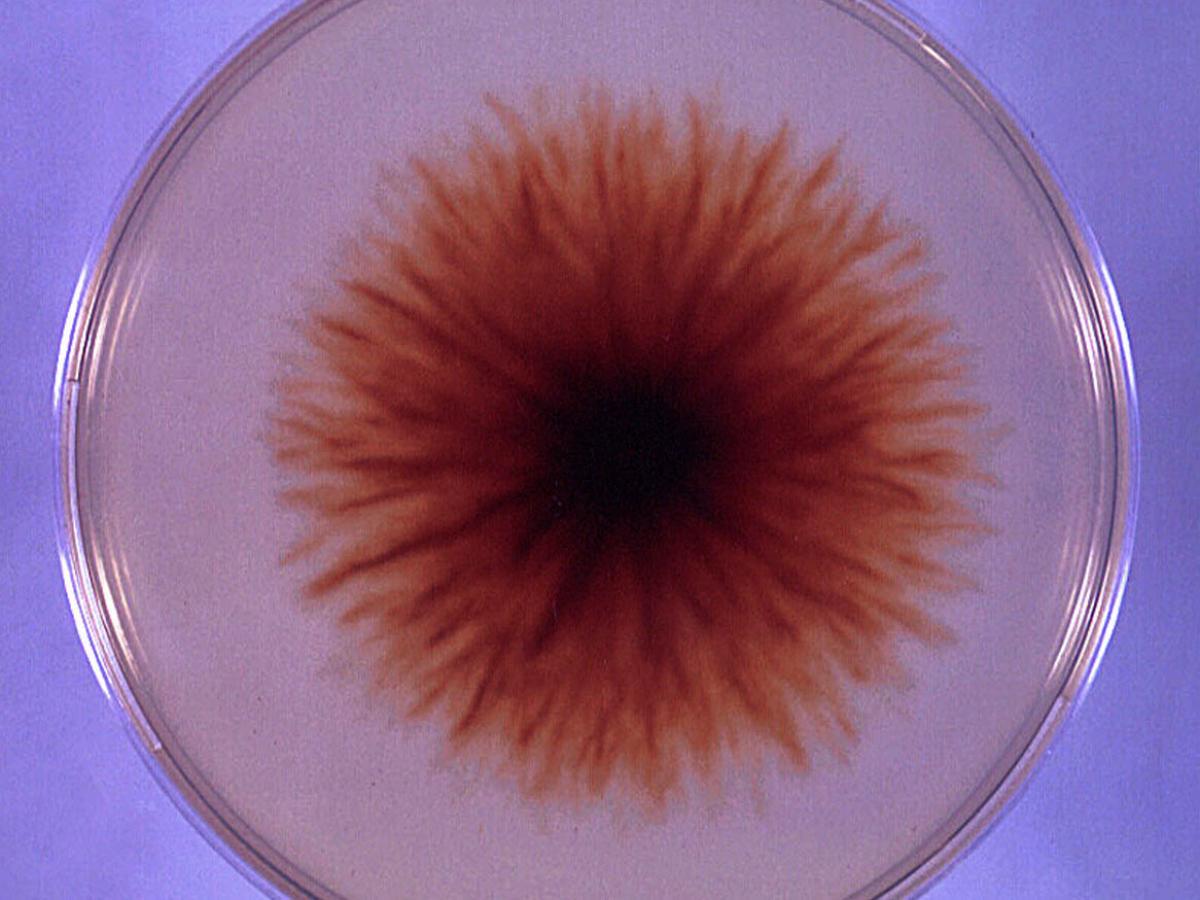
Culture

Unknown 47
Mould identification: a virtual self assessment
Case history
A 53-year-old male abattoir worker presented with an erythematous, scaly and pustular lesion on his wrist. Direct microscopy showed the presence of fungal hyphae and the culture shown below was isolated.

Clinical presentation
Culture
Culture

Microscopy
